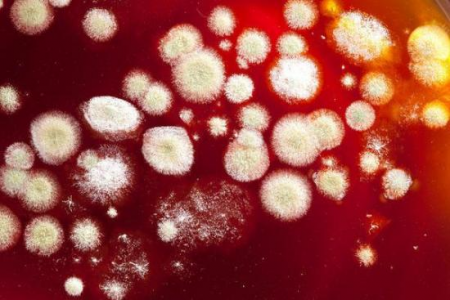
Дрожжевой грибок Дрожжевой грибок

Творожистые выделения и зуд в интимном месте у женщин

Выделения из влагалища: норма
Процесс очищения влагалища у женщин посредством выделений вполне естественен. Нормальные выделения:
- скудные;
- прозрачные или беловатые;
- водянистые;
- без запаха и зуда (возможен чуть кисловатый запах).
Незначительное усиление выделений наблюдается до или после полового акта, в период овуляции (на 9 – 11 день после месячных). Уплотнение консистенции отделяемого секрета и некоторое его помутнение без появления зуда и неприятного запаха характерно перед менструацией.
В каких случаях следует обратиться в клинику?
Любое отклонение от нормы указывает на нарушение влагалищной среды. Поводом к медицинскому обследованию служит появление:
- творожистых белей;
- белых, желтоватых, коричневатых выделений;
- обильного количества отделяемого секрета;
- жжения и зуда в зоне промежности;
- резкого запаха.
Важно! Указанные симптомы могут быть постоянными или проявляться периодически. В любом случае они указывают на отклонение и требуют медицинской помощи.
Причины возникновения неприятных симптомов в интимном месте
Измененные выделения (бели) большинство женщин оправдывают молочницей и относятся к ним достаточно легкомысленно. Однако причин таких отклонений может быть множество, порой они указывают на серьезные недуги половой сферы, способные спровоцировать бесплодие.
Молочница
Около 95% женского населения в разные периоды жизни страдало молочницей. Однако присутствие грибов рода Candida в агрессивном состоянии не является нормой. Причины возникновения молочницы:
- прием антибиотиков;
- несоблюдение гигиены (в том числе использование интимных гелей, длительное употребление тампонов и ароматизированных прокладок на каждый день, синтетическое нижнее белье и т. д.);
- переохлаждение;
- снижение общей иммунной защиты;
- гормональные сбои;
- беспорядочная половая жизнь.
Классическая картина кандидоза: внезапное появление сильного зуда в интимной зоне, белые выделения хлопьями и гиперемия половых губ. Однако чаще всего выраженная симптоматика наблюдается только в первые дни от начала грибковой инфекции. Постепенно бели становятся более жидкими, уменьшается зуд. Хроническая молочница может развиваться годами, при этом болезненность может ощущаться только при половом контакте. Женщины лишь усиливают гигиену и принимают противогрибковые препараты и мази без назначения врача.
Важно! Частые спринцевания вымывают благоприятные молочнокислые бактерии из влагалища, тем самым провоцируя молочницу.
Бактериальный вагиноз
Этот недуг зачастую развивается на фоне молочницы. Изменение влагалищной среды провоцирует развитие патогенных бактерий. При этом наблюдается изменение цвета белей (желтые) и появление запаха тухлой рыбы.
Эрозивное поражение шейки матки
Появление эрозивного дефекта на слизистой шейки матки можно назвать следующим этапом развития бактериального вагиноза. При этом прозрачные бели, белые выделения и зуд во влагалище наблюдаются перед месячными. Шеечная эрозия относится к предраковым состояниям.
Половые инфекции
Различные венерические инфекции могут спровоцировать выделения и зуд. Уроплазмоз и хламидиоз часто проявляются водянистыми белями и незначительным зудом, возникающим вследствие раздражения нежной слизистой влагалища. Заболевания нередко протекают абсолютно бессимптомно и выявляются только при обследовании по причине бесплодия.
Яркая картина гонореи — белые творожистые выделения, нередко густой гной и боли при мочеиспускании. Трихомоноз проявляется коричневатыми или грязно-серыми выделениями и болезненностью внизу живота.
Сложность дифференциации половых инфекций только по симптоматической картине заключается в том, что большинство таких заболеваний протекает со стертыми симптомами, и нередко диагностируется сразу два и более типа патологических микроорганизмов.
Воспалительные заболевания половых органов
Цервицит характеризуют обильные водянистые выделения в предменструальный период. Хроническое воспаление может привести к гнойному процессу, что в значительной степени затрудняет лечение.
Эндометриоз и полипы характеризует скудное коричневатое (иногда кровянистое) отделяемое перед месячными, боли внизу живота. Данная патология чревата бесплодием, выкидышами и онкопатологией.
Заболевания внутренних органов и систем
Неприятные симптомы в промежности иногда являются симптомами внутренних заболеваний. Сахарный диабет характеризует сильнейший зуд и жжение половых губ, особенно выраженный по утрам. Возникает он на фоне частых позывов к мочеиспусканию.
Раздражение, зуд в промежности и творожистые выделения могут сигнализировать о развитии сенсибилизации к применяемым медицинским препаратам (пероральным контрацептивам, влагалищным суппозиториям и т. д.).
Заболевания почек, особенно тяжелые, характеризуются появлением в моче лейкоцитов и эритроцитов. Нередко выделяемый из мочеиспускательного канала гной вызывает раздражение в интимном месте, покраснение и зуд кожи. При этом перед мочеиспусканием некоторые пациентки отмечают выделение гнойных капелек или беловатых выделений из мочеиспускательного канала.
Зуд и жжение при беременности
Специфический запах и изменение количества влагалищного секрета при беременности считается нормой. Это связано с гормональной перестройкой организма и физиологическим изменением влагалищной среды. Однако выраженные неприятные признаки, сильно беспокоящие беременную женщину, могут указывать на одну из вышеперечисленных причин. Сохранение беременности требует при этом срочного врачебного обследования и своевременного лечения.
Диагностика
Зуд и творожистые выделения полностью устраняются только при правильном назначении лечения. Для этого необходимо выяснить истинную причину беспокойства женщины. На приеме гинеколог проводит следующие манипуляции:
- тщательный сбор анамнеза (половая грамотность пациентки, нюансы ее интимной гигиены, сопутствующие заболевания и т. д.);
- гинекологический осмотр и взятие мазка на влагалищную микрофлору/ПЦР;
- обследование влагалища с помощью зеркал и кольпоскопия;
- УЗИ (при необходимости трансвагинальное);
- исследование гормонального фона (по показаниям);
- анализы крови на инфекции.
Лечение патологических влагалищных выделений и зуда
Схема лечения и необходимость инструментальных вмешательств (криодеструкция или диатермокоагуляция и воздействие ультразвуком) определяются согласно установленному диагнозу. При лечении патологических выделений, сопровождающихся зудом, требуется соблюдения следующих правил:
- Самолечение лекарственными препаратами и народными средствами, скорее всего, приведет к хронизации и усугублению патологического процесса и значительно повысит риск осложнений.
- Своевременное обращение в медицинское учреждение — залог правильной постановки диагноза и успешного лечения.
- Перед походом к гинекологу не следует спринцеваться, достаточно обычного подмывания наружных половых органов.
- Эффективное лечение с оптимальным подбором медицинских средств и процедур может назначить только квалифицированный специалист-гинеколог. Нередко для назначения специфического лечения необходима консультация других узкопрофильных специалистов (онколога, венеролога и эндокринолога).
- Медикаменты, избавившие ваших знакомых от патологических выделений, не всегда будут эффективны и целесообразны для вас.
- Только точное соблюдение врачебных рекомендаций избавит от появления осложнений и исключит риск хронизации выявленной патологии.
- Нередко требуется одновременное лечение полового партнера.
Патологические выделения из влагалища у женщин, сопровождающиеся резким запахом, жжением и болезненностью, не стоит оставлять без внимания. Своевременная консультация гинеколога порой позволяет избежать бесплодия, а иногда, например, при выявлении онкологии, сохраняет жизнь пациентке.













Добавить комментарий